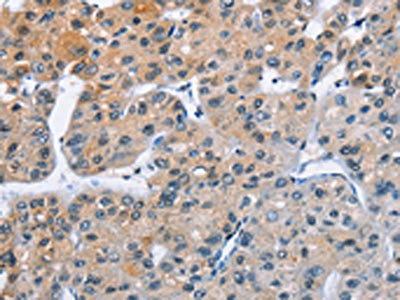

ATXN1 Antibody
-
中文名稱:ATXN1兔多克隆抗體
-
貨號:CSB-PA219113
-
規格:¥1100
-
圖片:
-
The image on the left is immunohistochemistry of paraffin-embedded Human thyroid cancer tissue using CSB-PA219113(ATXN1 Antibody) at dilution 1/40, on the right is treated with fusion protein. (Original magnification: ×200)
-
The image on the left is immunohistochemistry of paraffin-embedded Human liver cancer tissue using CSB-PA219113(ATXN1 Antibody) at dilution 1/40, on the right is treated with fusion protein. (Original magnification: ×200)
-
Gel: 6%SDS-PAGE, Lysate: 40 μg, Lane 1-2: 293T cells, human fetal brain tissue, Primary antibody: CSB-PA219113(ATXN1 Antibody) at dilution 1/800, Secondary antibody: Goat anti rabbit IgG at 1/8000 dilution, Exposure time: 20 seconds
-
-
其他:
產品詳情
-
Uniprot No.:
-
基因名:
-
別名:alternative ataxin1 antibody; Ataxin-1 antibody; ATX1 antibody; ATX1_HUMAN antibody; Atxn1 antibody; D6S504E antibody; OTTHUMP00000016065 antibody; SCA1 antibody; Spinocerebellar ataxia type 1 protein antibody
-
宿主:Rabbit
-
反應種屬:Human,Mouse,Rat
-
免疫原:Fusion protein of Human ATXN1
-
免疫原種屬:Homo sapiens (Human)
-
標記方式:Non-conjugated
-
抗體亞型:IgG
-
純化方式:Antigen affinity purification
-
濃度:It differs from different batches. Please contact us to confirm it.
-
保存緩沖液:-20°C, pH7.4 PBS, 0.05% NaN3, 40% Glycerol
-
產品提供形式:Liquid
-
應用范圍:ELISA,WB,IHC
-
推薦稀釋比:
Application Recommended Dilution ELISA 1:2000-1:5000 WB 1:500-1:2000 IHC 1:50-1:200 -
Protocols:
-
儲存條件:Upon receipt, store at -20°C or -80°C. Avoid repeated freeze.
-
貨期:Basically, we can dispatch the products out in 1-3 working days after receiving your orders. Delivery time maybe differs from different purchasing way or location, please kindly consult your local distributors for specific delivery time.
-
用途:For Research Use Only. Not for use in diagnostic or therapeutic procedures.
相關產品
靶點詳情
-
功能:Chromatin-binding factor that repress Notch signaling in the absence of Notch intracellular domain by acting as a CBF1 corepressor. Binds to the HEY promoter and might assist, along with NCOR2, RBPJ-mediated repression. Binds RNA in vitro. May be involved in RNA metabolism. In concert with CIC and ATXN1L, involved in brain development.
-
基因功能參考文獻:
- These convergent evidences support ATXN1 as a promising risk gene for Schizophrenia, and the integrated approach serves as a useful tool for dissecting the genetic basis of schizophrenia. PMID: 29055568
- JNK and DUSP18 reciprocally modulate the SUMOylation, which plays a regulatory role in the aggregation of ataxin-1. PMID: 29852174
- ATXN1 might contribute to neuronal degeneration leading to ALS. PMID: 29274668
- SCA1 mutation carriers performed similarly to controls in the postural tasks with open eyes, whereas in conditions without visual feedback SCA1 carriers had significantly higher stability index than controls at all longitudinal evaluations. Close-to-disease onset carriers (PMID: 28551466
- In cervical cancer cells, ATXN1 knockdown induced EMT by directly regulating Snail expression, leading to matrix metalloproteinase activation and the promotion of cell migration and invasion. PMID: 28212558
- ATXN1 underexpression is associated with metabolic diseases. PMID: 27918534
- data suggest GSK3b and mTOR pathways modulate this ATXN1 function in spinocerebellar ataxia type-1 (SCA1)pathogenesis that could be targeted therapeutically prior to the onset of disease symptoms in SCA1 and other pathologies involving dysregulation of ATXN1 functions. PMID: 27466200
- SCA1 phenotypes could be reversed by partial suppression of human mutant ATXN1 mRNA by rAAV.miS1 when delivered after symptom onset in mice. PMID: 27686464
- SCA1 relative frequency in Poland shows the highest value compared with the data from other countries worldwide in patient with Spinocerebellar ataxias PMID: 27193757
- Studied Ataxin-1 using molecular modeling to investigate the protein-protein interactions contributing to the AXH domain dimer stability. PMID: 26879337
- Data indicate that in spinocerebellar ataxia type 1 patients the spinocerebellar ataxia type 1 protein trinucleotide repeat expansion (CAG)n was great than 39, comparing with normal 6-38. PMID: 27577232
- This study reports the results of molecular dynamics simulations of AXH monomer of Ataxin-1. PMID: 26522012
- Systematic replacement of each lysine residue in the AXH domain revealed that the lysine at 589 (K589) of ATXN1 is essential for its ubiquitylation by UbcH6. PMID: 25641559
- Results show that two SNPs in ATXN1 gene have a founder effect of the same repeat carrying allele as in the general Indian population suggesting that that Spinocerebellar ataxia type 1 disease onset is significantly delayed when transmission is maternal. PMID: 25344417
- this work provides the structural and molecular basis of the interaction between RBM17 and the phosphorylated form of ATXN1. PMID: 24858692
- Partner recognition of the AXH domain of the transcriptional co-regulator ataxin-1 is fine-tuned by a subtle balance between self- and hetero-associations. PMID: 24155902
- We measured cerebellar neurochemical alterations in a knock-in mouse model of spinocerebellar ataxia type 1, a hereditary movement disorder, using ultra-high field magnetic resonance spectroscopy (MRS). PMID: 24032423
- Data indicate that the alternative ataxin-1 (ATXN1) protein is constitutively co-expressed and interacts with ATXN1. PMID: 23760502
- SCA 1 was the most frequent occurring type of SCA identified in the Autosomal dominant hereditary ataxia in Sri Lanka. PMID: 23634774
- Results show variation in ATXN1 is implicated in disordered gambling PMID: 22780124
- conformational heterogeneity of the AXH domain of ataxin-1 PMID: 23528090
- Patients carrying JARID2 deletion manifested with cognitive impairment, gait disturbance and a characteristic facial appearance, whereas patients with deletion of ATXN1 seemed to be characterized by intellectual disability and behavioural abnormalities PMID: 23294540
- multiple components of the RAS-MAPK-MSK1 pathway influence ATXN1 levels in Drosophila and human cells PMID: 23719381
- This study showed that develop progressive cerebellar degeneration requires expressing ATXN1 with an expanded polyglutamine tract. PMID: 23536093
- Both ATXN-1 and ATXN-2 PolyQ intermediate expansions are independently associated with an increased risk for ALS. PMID: 23197749
- MED15 and PUM1 proteins with coiled-coil domains are potent enhancers of polyQ-mediated ataxin-1 protein misfolding and proteotoxicity in vitro and in vivo. PMID: 22916034
- FOX-2 is involved in splicing of ataxin-2 transcripts and that this splicing event is altered by overexpression of ataxin-1 PMID: 22666429
- Data indicate that neuroprotectin D1 (NPD1) synthesis is an early response induced by proteotoxic stress due to abnormally folded ataxin-1. PMID: 22511762
- results suggest that expanded ATXN1 may induce unregulated ionic pathways in the nuclear membrane, causing severe damage to the cell PMID: 22330095
- This study demonistrated that Disease progressed of autosomal dominant cerebellar ataxia and spastic paraplegia faster in SCA s with polyglutamine expansions in SCA1, 2, and 3. PMID: 22491195
- Both ATXN1 and BOAT1 bind to the promoter region of Hey1 and inhibit the transcriptional output of Notch through direct interactions with CBF1, a transcription factor that is crucial for the Notch pathway. PMID: 21475249
- This study demonstrates that ataxin-1 occupies the promoter region of E-cadherin in vivo and that ataxin-1 activates the promoter in a CtBP2-mediated transcriptional regulation manner. PMID: 21315774
- The ATXN1 gene is related to intelligence in an ADHD background. PMID: 21302343
- Phosphorylation of transgenic ataxin-1 at the serine-776 motif is critical for ataxin-1 mediated toxicity. PMID: 20477910
- ATXN1 functions as a genetic risk modifier that contributes to AD pathogenesis through a loss-of-function mechanism by regulating beta-secretase cleavage of APP and Abeta levels PMID: 20097758
- The neurochemical alterations detected in SCA1[82Q] transgenic mice are primarily due to expansion of the polyglutamine repeat in ataxin-1, rather than the overexpression of the human protein. PMID: 20220018
- Together these results indicate that SUMO modification of ataxin-1 promotes the aggregation of ataxin-1 and that oxidative stress and JNK pathway play roles in this process. PMID: 20132795
- p62 contributed to the assembly of proteasome-containing degradative compartments in the vicinity of nuclear aggregates containing polyglutamine-expanded Ataxin1Q84 and to the degradation of Ataxin1Q84. PMID: 20018885
- in spinocrebellar attaxia, a trinucleotide expansion disease...a possible role of this SCA1 allele with 31 repeats in triplet diseases...a possible role of the SCA1 region in pathological trinucleotide repeat expansions. PMID: 11807410
- Spinocerebellar ataxia type 1 (SCA1): phenotype-genotype correlation studies in intermediate alleles PMID: 11973625
- Two types of ataxin1 inclusions exist; those undergoing rapid, complete exchange with a nucleoplasmic pool, and those that contain varying levels of slow-exchanging ataxin1. The latter inclusions contain high ubiquitin levels, but low proteasome levels. PMID: 12360291
- phylogenetic evidence from deletions in SCA1 PMID: 12411613
- p80 coilin protein co-localizes with ataxin-1 aggregates in the nucleoplasm PMID: 12757932
- analysis of SCA1 AXH domain structure PMID: 14583607
- We demonstrate that abolishing full-length mutant human ataxin-7 transgene expression did not reverse retinopathy progression in SCA7 mice, raising the possibility that some polyQ-induced pathological events might be irreversible. PMID: 14985428
- the structural role of the CAU interruptions in the SCA1 transcripts that destabilize the CAG repeat hairpin PMID: 15292212
- SCA1 genotypes in a Polish population are significantly different in allele spectra & frequencies from other populations. The dynamic mutation of SCA1 may begin from the expansion of long pure repeat tracts without the prior loss of interruptions. PMID: 15300851
- Ataxin-1 localization to inclusions and inclusion dynamics within the nucleus are RNA- and transcription-dependent. PMID: 15615787
- polyglutamine-expanded ataxin-1 decreases the activity of the proteasome, implying that a disturbance in the ubiquitin-proteasome pathway is directly involved in the development of spinocerebellar ataxia type 1 PMID: 15750336
- A novel phosphorylation site at serine 239 was demonstarted in ataxin-1. PMID: 15878393
顯示更多
收起更多
-
相關疾病:Spinocerebellar ataxia 1 (SCA1)
-
亞細胞定位:Cytoplasm. Nucleus.
-
蛋白家族:ATXN1 family
-
組織特異性:Widely expressed throughout the body.
-
數據庫鏈接:
Most popular with customers
-
-
YWHAB Recombinant Monoclonal Antibody
Applications: ELISA, WB, IHC, IF, FC
Species Reactivity: Human, Mouse, Rat
-
Phospho-YAP1 (S127) Recombinant Monoclonal Antibody
Applications: ELISA, WB, IHC
Species Reactivity: Human
-
-
-
-
-